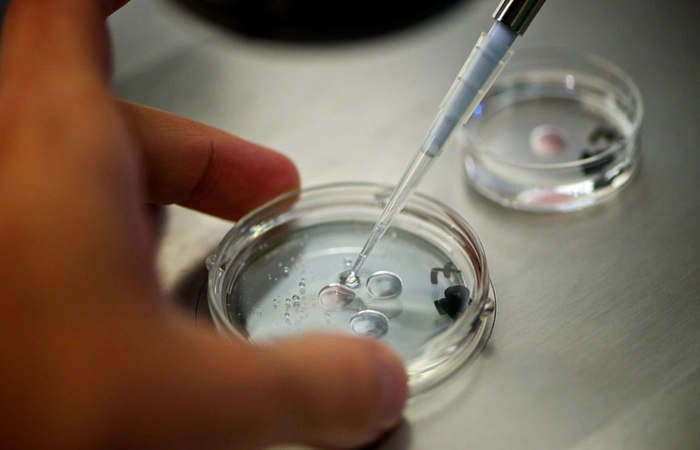

ICSI Fertility Centre in Coimbatore with Expert Doctors
Couples are being suggested ICSI when they face severe male infertility, low sperm count, or repeated IVF failures to increase fertilization chances. At Feto IVF Fertility Centre in Coimbatore, we perform ICSI gently and precisely. Our experts and professionals select a healthy sperm and inject it directly into an egg, thereby increasing the chances of getting pregnant and also guiding you towards your parenthood. We use advanced technology and proven techniques to ensure the highest quality of results. Every step is personalized to the couple’s unique needs, making the journey to parenthood as smooth and hopeful as possible.
What is ICSI?
Intracytoplasmic Sperm Injection (ICSI) is an advanced infertility procedure that is used to treat couples that are severely infertile with particular male infertility pertaining to low sperm count, poor sperm motility, or irregular sperm morphology. In the process, a single healthy sperm is carefully selected and inoculated directly into a fully developed egg within the laboratory, thereby increasing the chances of conception. When fertilization has taken place, the embryo gets implanted into the womb of the woman, which gives hope to couples who have already undergone several attempts of IVF or those who do not conceive naturally. ICSI combines accuracy, expertise, and technology in order to guarantee maximum probability of successful pregnancy, besides providing personalized care during the course of parenthood.
When to Consider ICSI Fertility Treatment in Coimbatore
- You have tried for at least one year (six months in the case of women above 35) to conceive naturally to no avail.
- Past fertility therapy, including medications, IUI, or IVF no longer proved to cause pregnancy.
- You have a very low sperm count, poor motility, or abnormal sperm shape, which are very severe factors of male infertility.
- An earlier IVF failed in the presence of healthy eggs and sperm.
- You would like to employ sperm retrieved by surgery, like in azoospermia, when the semen itself does not contain sperm.
- You wish to improve the probability of fertilization in case of a limited number of eggs, which you have since you have low ovarian reserve.
- You require specialist advice and specialized help to proceed to parenthood using the latest fertility methods.

How Does ICSI Work at Feto IVF Fertility Centre in Coimbatore?
Issue Identification
Both partners undergo detailed evaluation to understand underlying issues and decide if ICSI is the right choice.
Problem Rectification
Any medical or lifestyle factors affecting fertility are addressed before treatment begins.
Ovarian Stimulation
The woman receives medications to help the ovaries produce multiple mature eggs for fertilization.
Egg Retrieval
Mature eggs are collected from the ovaries using a minor procedure under safe monitoring.
Sperm Collection
A semen sample is obtained or sperm is retrieved surgically if needed.
Direct Fertilization
A single healthy sperm is carefully injected into each mature egg under advanced microscopes.
Embryo Development
Fertilized eggs are observed as they grow into embryos in the laboratory.
Embryo Transfer
The best quality embryo is gently placed in the womb.
Pregnancy Test
A blood test after 12 to 14 days confirms the success of implantation.
Trying to Conceive? Know Your Infertility Conditions
Women Infertility Disorders
- Repeat Miscarriages and Pregnancy Loss - We apply PGT or non-invasive embryo screening to choose the healthiest embryos to increase the likelihood of successful fertilization and pregnancy.
- Endometriosis and Severe Period Pains - Fertility surgeries and laser embryo hatching improve the implantation and provide women with complex conditions a better chance of conceiving.
- Uterine Problems - Fertility-optimizing surgeries and ERA testing help in making the womb available at the perfect time when the embryo implantation occurs.
- Ovarian Problems - Therapies such as Ovarian PRP therapy and cryopreservation improve egg quality and maintain fertility, particularly prior to the ICSI cycles.
- Blocked Fallopian Tubes - Sperm is directly introduced into eggs during ICSI to avoid blockages, and in order to protect future fertilization, cryopreservation can be employed.
- Unexplainable Infertility- ERA testing and laser hatching are used to improve better embryo implantation by providing specific solutions where other causes are not evident.
Male infertility disorders
- Low Sperm Count (Olygospermia) - Techniques like PESA or TESA harvest healthy sperm directly to undergo ICSI fertilization without any natural constraints
- No Sperm (Azoospermia)— Sperm that have been surgically collected through PESA or TESA are being injected into oocytes, and fertilization occurs during cases of severe male infertility.
Why Trust Feto IVF Fertilization Center for ICSI in Coimbatore?

Individualized Fertility Care Plans
Each couple gets personal attention and treatment is tailored to match specific health requirements and improve fertilization with accuracy.

Advanced Laboratory Equipment
We have high-resolution microscopes and sophisticated culture systems in our lab that provide safety in handling of egg, sperm and embryo during the ICSI process.

Caring & Helpful Services
During all the processes, such as testing, transfers of the embryo, and so on, we assist couples mentally and physically with Yoga and other proven weight management programs.
Schedule Your ICSI Appointment with Our Fertility Specialists
Take the next step toward parenthood with personalized ICSI treatment. Our specialists combine advanced techniques and compassionate support to improve your chances of a healthy pregnancy.